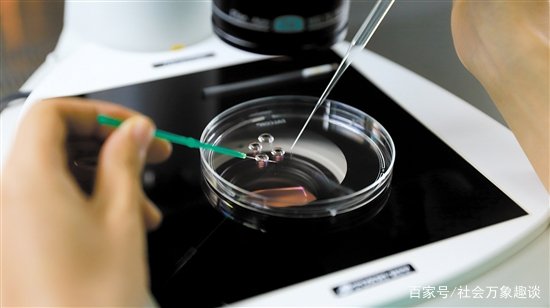
广东一女子在分娩的时候去世,丈夫欲取冷冻胚胎遭拒,你如何看待此事?

广东一女子在分娩的时候去世,丈夫欲取冷冻胚胎遭拒,你如何看待此事?
的有关信息介绍如下:在分娩的时候去世确实很让人心痛,丈夫索取冷冻胚胎遭拒这让很多人都感觉不解,我觉得对于这件事应该从法律层面、技术条件层面和情感层面来看待。

其实问题很简单,这个冷冻的胚胎毫无疑问是属于广东这名女子以及他的家人的,所以我觉得她的丈夫索取这个胚胎很正常,医院按照正常的思路也应该积极配合。但是由于他的妻子已经去世,将这个胚胎直接给这名男子,很有可能使其走其他非法渠道来生孩子,这也会给医院带来风险,毕竟我国并没有完全放开胚胎移植,对胚胎移植有着很高的要求。
所以医院要想避免自己的风险,最好是拒绝并让对方走法律程序妥善解决,这样对双方都是一种保护。

我觉得医院拒绝也是有原因的,毕竟胚胎的保管是一项专业性很强的工作,对外界条件有着很高的要求,这名男子家中根本就没有保存胚胎的条件,一旦胚胎从医院取出,很与可能因为保管不当而出现问题。
我觉得医院拒绝也是很有道理的,很多人并不知道保管冷冻胚胎的条件有多麽苛刻,其实只有找好下一个存放地点或者准备实施胚胎移植医院才能移交,所以这名男子并不具备这些条件,所以医院的行为其实是很负责任的行为,应该点赞。
毫无疑问,从个人情感方面来看,医院应该移交,毕竟妻子去世了,哪个冷冻的胚胎是他和妻子爱情的结晶,他想要把这个胚胎利用起来,保存自己对妻子的怀念。我觉得这无可厚非,从情感的角度,我觉得医院应该支持他。但是越是在这个时候,我觉得越是要理性,医院即使给这名男子,他也很难利用,所以我觉得双方主要是没有认真沟通,很多事情男人并不知道,我觉得当男子理性下来,医院将所有的问题都告知并帮助其分析之后,这名男子会做出理性的选择。
尽管后来闹到了法院,也将这个冷冻胚胎判给了这名男子,但是依然要求该男子妥善保管并不得非法代孕,所以我觉得在条件尚不具备的情况下,将胚胎存放在医院是最好的选择,待未来时机成熟时在使用也许会更好。



